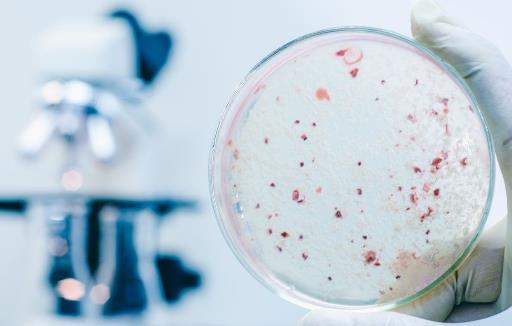
益生菌或解開長壽密碼 補充益生菌可長壽

益生菌或解開長壽密碼 補充益生菌可長壽
每個人都希望自己擁有一個健康的身體,是每個人也希望自己擁有一個非常長的壽命,這樣子才可以有更多的時間想做自己做的事情,但是怎么樣子才可以讓我們的身體更加健康,讓我們的生命更加長呢?下面360常識網就為大家介紹一種可能是長壽密碼的一種細菌。

研究發布關于益生菌最新科研成果:腸道菌群分型或解生命密碼。介紹了腸道菌群很有可能是解密長壽的密碼。腸道菌群與肥胖、糖尿病、心血管疾病、精神疾病、腫瘤等慢性疾病息息相關,腸道菌群失衡可能會引發多種疾病。所以維持*腸道菌群平衡尤為重要!
近年來,科學家開始從我們的腸道菌群里尋找生命密碼。
對有益的細菌我們叫它益生菌,它可以平衡腸道的PH值,促進體內菌群平衡,從而讓身體更健康。腸道掌管著70%以上的免疫功能。如果說腸道是免疫力的培訓基地,益生菌就是培訓員。
益生菌其他的作用:
1、增強*免疫力;
2、緩解過敏作用;
3、預防真菌感染;
4、降低血清膽固醇;
5、預防癌癥和抑制腫瘤生長;
6、保護肝臟和腎;
7、解決腸易激綜合癥導致的長期腹瀉、便秘;
8、維護吸煙者的健康。
益生菌可以快速分解降解或吸附致癌細胞,從而減輕其毒性,還能產生抑制腫瘤細胞生長的化合物,殺死有害細菌新陳代謝物,從而防止破壞細胞的DNA,起到抑制、延緩癌癥生長的作用。

平衡腸道菌群,增進腸道健康
1、和腹瀉便秘說bye bye 腸道好輕松有益菌能幫助刺激腸壁蠕動,有利于排便、清理腸道,可減少有毒腐敗產物在*內的滯留時間,同時降低腸炎、慢性腹瀉、腸癌等疾病的發病率。
2、提高機體免疫力 健康有活力你知道嗎,你的免疫力有七成來自于腸道!*有大量的免疫細胞,如T細胞、B細胞、自然殺傷細胞等都集中在腸道,對外界的病菌病毒進行第一道防線的阻擊。
除開腸道健康,有益菌還跟你的體重有著密不可分的聯系喲。
減少脂肪吸收 清理腸道廢物
1、減少脂肪吸收腸道有益菌能減少腸道對游離脂肪酸的吸收,從源頭上減少機體脂肪的合成及體重的增加。
2、控制食欲腸道菌群酵解產物可以使人增加飽腹感,抑制攝食并且防止飲食誘導的肥胖。
3、減少脂肪細胞增殖肥胖者處于一種慢性輕度炎癥的狀態,增加腸道有益菌可以改善慢性炎癥癥狀從而改善肥胖癥狀,不失為一種控制體重的方法。
除此之外,腸道菌群還可幫助分解*無法消化利用的多糖,為機體提供能量;促進多種礦物質營養在腸道的吸收;雙歧桿菌等還可以合成維生素B、K,合成*代謝所需的多種酶類。
20年前就有專家說過:未來能對抗癌癥的物質一定是益生菌發酵領域!請大家學會用益生菌,快速分解體內垃圾毒素,激活、修復、再生細胞,加快新陳代謝,排出毒素,一身輕松!
活性是關鍵
人體的消化道環境很復雜在經過胃酸、膽汁等環境后依然能存活的菌株才能到達大腸發揮其功效。
100萬個才有效。我國乳酸菌標準明確規定酸奶中活菌的數量要達到每毫升100萬個。否則就不能保證最終到達大腸的活菌量也就無法保證功效。
1.益生菌的獲取
市面上的益生菌產品包括含益生菌的酸奶、酸奶酪、酸豆奶以及口服液、片劑、膠囊、粉末劑等。最方便的當算是飲品類。
2.益生菌如何保存
益生菌產品必須低溫冷藏保存。這樣才能最大限度地保持其中活性益生菌的數量。一般保質期在1個月內冷藏溫度控制在2~10℃左右。建議放入冰箱保鮮層避免在溫度太高或者直射光下保存這樣會引起里面活菌過度發酵口味變酸效果受影響。

3.怎么進食
益生菌的活性會隨著溫度升高而提升并進入發酵過程長時間常溫保存容易造成產品口味變化。當溫度超過60℃時益生菌會進入衰亡階段。因此益生菌產品最好是在冷藏條件下取出后直接食用避免高溫加熱。
4.飲用量
一般來說每天喝1瓶約100ml以每瓶100億個活性乳酸菌計活性乳酸菌飲品就足以滿足人體所需。
5.最佳飲用時間
益生菌產品雖然也可以單獨食用但最佳食用時間為飯后。因為有食物中和胃酸更有利于活菌順利到達腸道發揮作用所以飯后飲用效果更佳。
6.補充益生菌
胃酸過多的人、胃腸道手術后的病人、心內膜炎和重癥胰腺炎患者不宜多喝益生菌酸奶最好事先咨詢醫生其他人則可以盡情享用。一般出生3個月后的嬰幼兒即可開始逐漸補充一些含有益生菌的乳制品。對于孕期容易產生便秘等問題的孕婦來說補充益生菌也是非常有幫助的且一般隨著年齡增加腸內有害菌增多所以成年人及老年人更需要補充益生菌。
